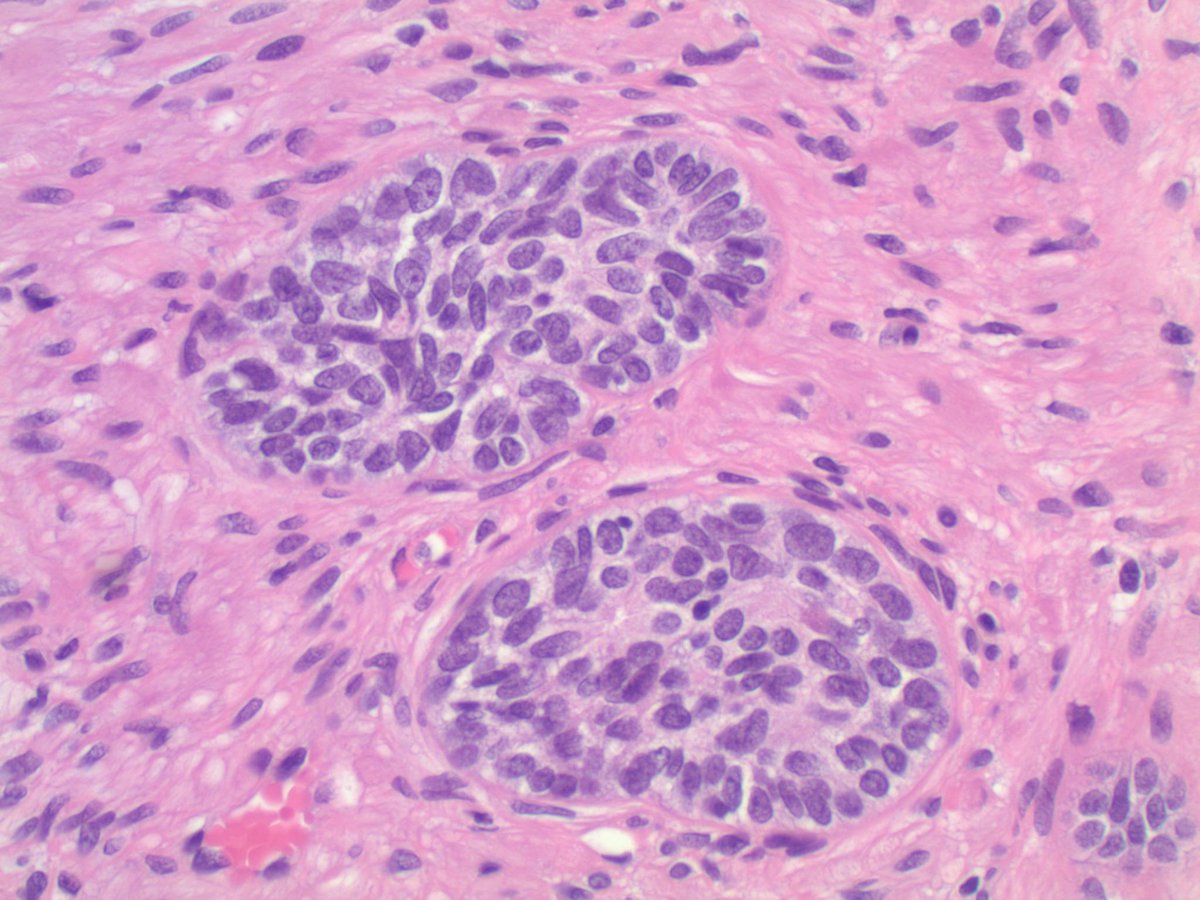

Sanica Bhele
@sanicabhelemd
@TheABPath certified/Fellowship trained ❤️#ENTpath #GUpath #GynPath, alum @TataMemorial 🇮🇳 💕🧘♀️🎼📖👩🏻🍳 T/RT ≠ MedAdvice, views r my own
ID: 1065956713629696002
https://www.researchgate.net/profile/Sanica-Bhele 23-11-2018 13:14:19
1,1K Tweet
1,1K Followers
539 Following



4.3 cm renal mass confined to kidney, tumor cells are predominantly with proliferative, tubular pattern 🎨 CK7 positive (strong, diffuse) 🎨 CD117 negative Thoughts? Sean R Williamson MD Kiril_T_Can Michelle_Hirsch (Donovan) Priya Rao, MD Ankur Sangoi






Kidney, young F adult #gupath Dr. Luca Olaleke Folaranmi Aurélien Morini, MD, MSc 🇫🇷🇪🇺💙💛 Celina Stayerman MD 🔻Nusrat Zahra🔻🇵🇸 @miss_me1986 Gonzalo De Toro Tristan Rutland MBBS FRCPA IFCAP Anandi Lobo, MD Sumanta Das Lorand Kis Erik Kouba bansar Carlos Miguel Ruiz Carlos Nieves Padma Priya J Susan Prendeville @AkgulMd Ankur Sangoi Barry McGinn






Day 2 successfully completed USCAP ... #USCAP2023 has been a great experience so far. Connecting with old friends Sanica Bhele Nandan Padmanabha Ruchi and making new ones Hansini Laharwani ... CAPathologists Baystate Health


Representing WashU Medicine Pathology & Immunology Education @wusm_pathology. Always great to see our trainees at #USCAP2023 #USCAP23


What role does DICER1 play in #ThyroidCancer? Our analysis suggests indolent pediatric DICER1-mutated tumors may develop additional DICER1 mutations, leading to more aggressive behavior. Check out Sanica Bhele’s presentation for more. carislifesciences.com/publications #USCAP2023


Proud of our #ENTpath fellow Sanica Bhele. Visit our poster WashU Medicine Pathology & Immunology Education @wusm_pathology #USCAP2023 #USCAP23


Finally got a chance to meet Adam L. Booth, MD Thanks for your business advice 😜. It was nice meeting you! #USCAP2023 #NOLA #GIpath #pathologists #PathTwitter Hariharan Bharadwaj MD Sanica Bhele


We had a great time at #uscap2023! Notably, Sanica Bhele won Runner-up Best Poster by a Trainee award, and Hansini Laharwani won a special recognition award from Ace My Path. Read more about highlights from USCAP 2023 on our website: pathology.wustl.edu/department-of-… #PathTwitter WashU Medicine Pathology & Immunology Education